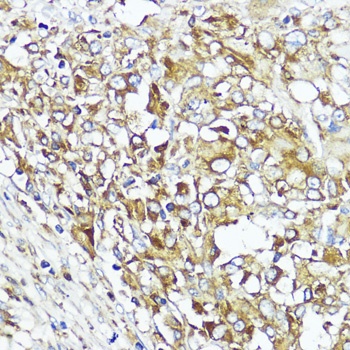
MLKL Antibody
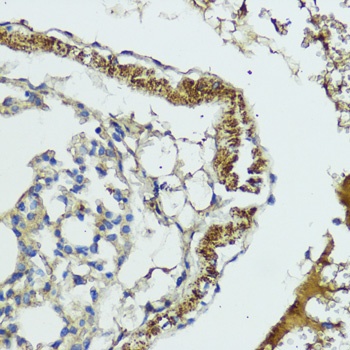
MLKL Antibody

You have no items in your shopping cart.
Mlkl antibody
Description
Images & Validation
−| Tested Applications | ICC, IF, IHC-P, WB |
|---|---|
| Dilution range | WB: 1:200-2000, IHC-P: 1:100-500, IF/ICC: 1:100-500 |
Key Properties
−| Host | Rabbit |
|---|---|
| Clonality | Polyclonal |
| Isotype | IgG |
| Immunogen | KLH conjugated synthetic peptide derived from human Mlkl. Please contact us for the exact immunogen sequence. The peptide is available as orb374793. |
| Target | Mlkl |
| Molecular Weight | 54 kDa |
| Purity | Polyclonal antibodies are purified by peptide affinity chromatography |
| Conjugation | Unconjugated |
Storage & Handling
−| Storage | Maintain refrigerated at 2-8°C for up to 2 weeks. For long term storage store at -20°C in small aliquots to prevent freeze-thaw cycles. |
|---|---|
| Form/Appearance | 10 mM PBS, 0.02% sodium azide |
| Concentration | - 100 μg (in 200 μl): 0.5 mg/ml- 200 μg (in 400 μl): 0.5 mg/ml |
| Disclaimer | For research use only |
Alternative Names
−Similar Products
−MLKL Antibody [orb1939981]
ELISA, FC, ICC, IF, IHC, WB
Human, Mouse, Rat
Rabbit
Polyclonal
Unconjugated
100 μgMLKL Rabbit Polyclonal Antibody [orb581940]
IHC, WB
Bovine, Equine, Rat
Human
Rabbit
Polyclonal
Unconjugated
100 μlRat Mixed Lineage Kinase Domain Like Protein (MLKL) ELISA Kit [orb782074]
Rat
0.16-10 ng/mL
0.06 ng/mL
96 T, 48 T

Quality Guarantee
Explore bioreagents carefree to elevate your research. All our products are rigorously tested for performance. If a product does not perform as described on its datasheet, our scientific support team will provide expert troubleshooting, a prompt replacement, or a refund. For full details, please see our Terms & Conditions and Buying Guide. Contact us at [email protected].

IHC-P staining of human breast tumour tissue using Mlkl antibody (2.5 ug/ml)

Immunohistochemical staining of rat skin tissue using Mlkl antibody (2.5 ug/ml)

IHC-P image of human thyroid tumour tissue using Mlkl antibody (2.5 ug/ml)

Immunohistochemical staining of paraffin embedded rat thymus tissue using anti-Mlkl (2.5 ug/ml)

IHC-P staining of mouse lymph node tissue using anti-Mlkl (2.5 ug/ml)

WB analysis of rat heart (lane 1), mouse stomach (lane 2), rat liver (lane 3), rat spleen (lane 4), rat lung (lane 5), human breast cancer (lane 6) using Mlkl antibody (1 ug/ml)

Immunohistochemical staining of paraffin embedded rat stomach tissue using Mlkl antibody (2.5 ug/ml)

IF analysis of guinea pig heart tissue using anti-Mlkl (2.5 ug/ml)

Immunohistochemical staining of paraffin embedded guinea pig lung tissue using Mlkl antibody (2.5 ug/ml)

Western blot analysis of human breast tumour (lane 1), human thyroid tumour (lane 2), human lung cancer (lane 3), Hela cells (lane 4) using Mlkl antibody (1 ug/ml)

Immunofluorescence image of guinea pig heart tissue using anti-Mlkl (2.5 ug/ml)

IHC-P staining of guinea pig heart tissue using anti-Mlkl (2.5 ug/ml)
Quick Database Links
Documents Download
Request a Document
Protocol Information
Filter by Applications
Filter by Species
Giusy Rita Caponio 1, Alessandro Annunziato 2, Mirco Vacca 2, Graziana Difonzo 2, Giuseppe Celano 2, Fabio Minervini 2, Marianna Ranieri 1, Giovanna Valenti 1, Grazia Tamma 1, Maria De Angelis Nutritional, antioxidant and biological activity characterization of orange peel flour to produce nutraceutical gluten-free muffins Food Funct, (2024)
Xing Fan 1, Fang Lin 1, Yu Chen 2, Yuling Dou 1, Ting Li 1 3, Xinxin Jin 4, Jintao Song 2, Fang Wang Luteolin-7- O-β-d-glucuronide Ameliorates Cerebral Ischemic Injury: Involvement of RIP3/MLKL Signaling Pathway Molecules, (2024)
Applications
Reactivity
Sublethal necroptosis signaling promotes inflammation and liver cancer Immunity, S1074-7613(23)00234-0 (2023)
Zhang, Liansheng et al. BAD-mediated neuronal apoptosis and neuroinflammation contribute to Alzheimer's disease pathology iScience, 24, 102942 (2021)
Günther, Claudia et al. The pseudokinase MLKL mediates programmed hepatocellular necrosis independently of RIPK3 during hepatitis J Clin Invest, 126, 4346-4360 (2016)
Saleh, Danish et al. Chemical Library Screens to Identify Pharmacological Modulators of Necroptosis Methods Mol. Biol., 1857, 19-33 (2018)
Zhou, Huiling et al. RIP1/RIP3/MLKL-mediated necroptosis contributes to vinblastine-induced myocardial damage Mol Cell Biochem, 476, 1233-1243 (2021)
Fuchslocher Chico, Johaiber et al. The enhanced susceptibility of ADAM-17 hypomorphic mice to DSS-induced colitis is not ameliorated by loss of RIPK3, revealing an unexpected function of ADAM-17 in necroptosis Oncotarget, 9, 12941-12958 (2018)
Bittel, Miriam et al. Modulation of the extrinsic cell death signaling pathway by viral Flip induces acute-death mediated liver failure Cell Death Dis, 10, 878 (2019)
Choi, Solji et al. 1-Palmitoyl-2-linoleoyl-3-acetyl-rac-glycerol ameliorates chemoradiation-induced oral mucositis Oral Dis, 26, 111-121 (2020)
Frank, Tanja et al. Cell cycle arrest in mitosis promotes interferon-induced necroptosis Cell Death Differ, 26, 2046-2060 (2019)
Stolberg-Stolberg, Josef et al. Cartilage Trauma Induces Necroptotic Chondrocyte Death and Expulsion of Cellular Contents Int J Mol Sci, 21, 4204 (2020)
Mlkl antibody (orb32399)
Participating in our Biorbyt product reviews program enables you to support fellow scientists by sharing your firsthand experience with our products.
Login to Submit a Review